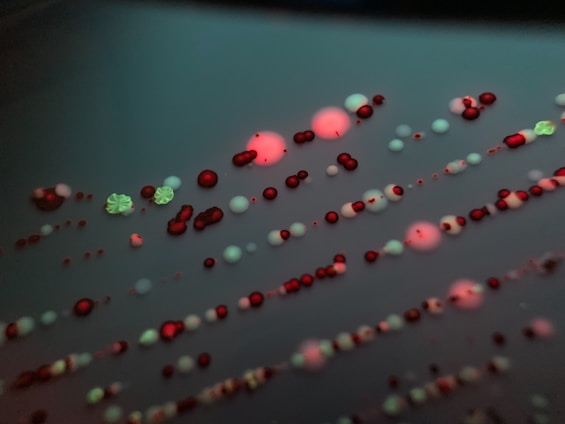

Microbiologia
Explore museus online dedicados à microbiologia fascinante.
Museus de Microbiologia
Explore a fascinante diversidade do mundo microbiano através de museus virtuais.

Museu da Vida – Fiocruz
Exposições virtuais sobre saúde, microrganismos e ciência, com recursos interativos e materiais educativos.


